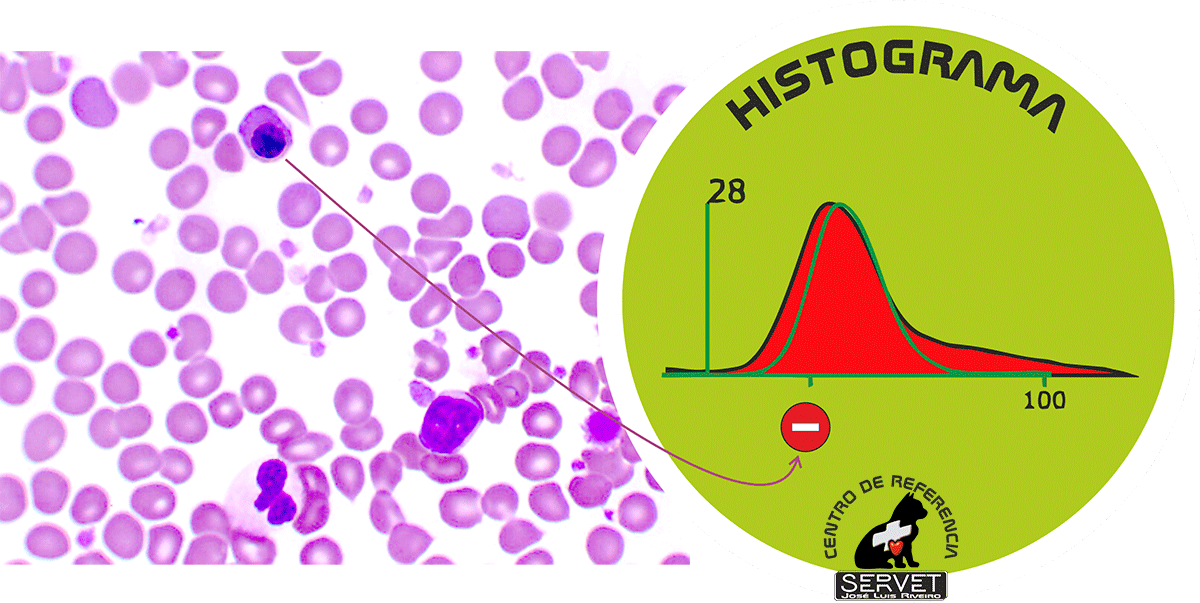

Células rojas nucleadas – histograma
Las células rojas nucleadas, no son contabilizadas por el equipo en el histograma de glóbulos rojos. En realidad, el equipo contará estas células en el scattergrama de glóbulos blancos, y los incluye ahí, debido a la presencia de núcleo en su interior.
Los eritrocitos nucleados (nRBC, del inglés Nuclear Red Blood Cell) son similares morfológicamente a los linfocitos. Pueden ser identificados erróneamente como linfocitos, produciendo un recuento total de leucocitos y linfocitos falsamente aumentado.
Que los nRBC están presentes en sangre implica necesariamente una elevadísima actividad eritopoyética. Una primera consecuencia de esta actividad es el aumento de reticulocitos que sí producen alteraciones en el histograma.
No es esperable la presencia de nRBC en sangre sin la presencia de reticulocitos.